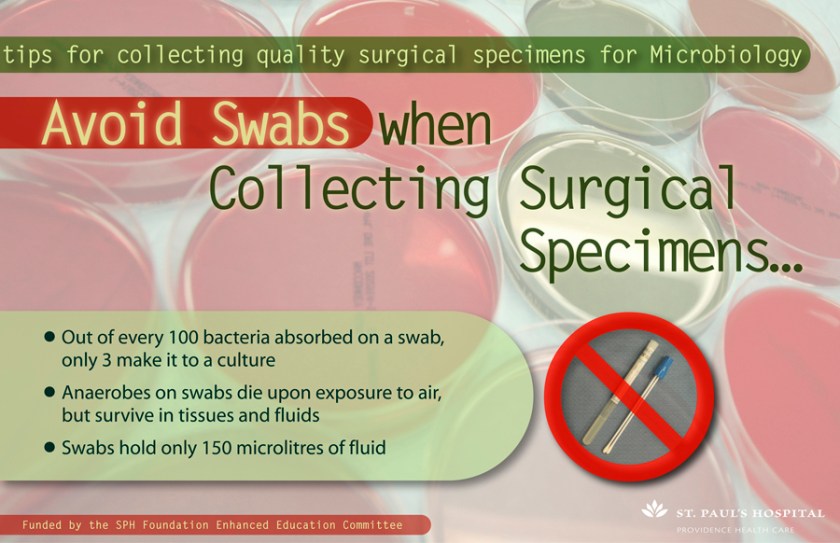
AvoidSwabs(lo-res) Avoid Swabs; 11"x17"; digital print
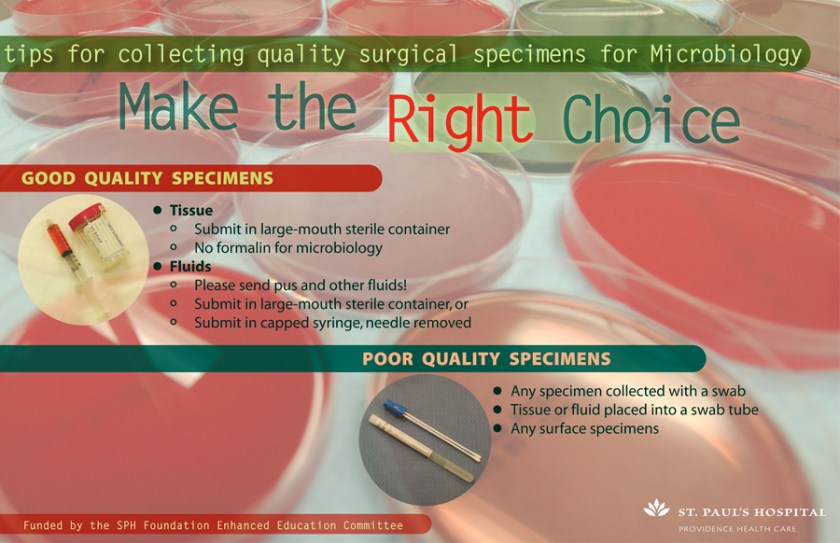
MaketheRightChoice(lo-res) Make the Right Choice; 11"x17"; digital print

For this poster, I used fragments of photos that were shot on a rainy, early morning walk to work along Hastings Street. It was well received and the next year I was asked to do 2 more posters. I made 2 different posters incorporating assorted photo images and was quite pleased with how they worked with the themes. Unfortunately, the client was not happy with them so they were never used.
poster
Poster for Aboriginal Risk Factor Study from 2005
graphic art, postersMicrobiology Swab Posters
graphic artThese posters were created in 2007 for the Microbiology Department at St. Paul’s Hospital to remind medical staff of effective methods for collecting samples. With minimal direction photographer, Brian K. Smith, shot the petri dishes in the microbiology lab which formed an interesting and colourful backdrop for the text.